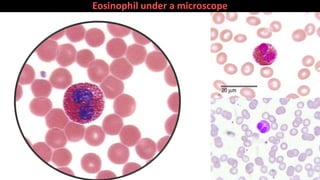
Eosinophil under a microscope

Blood is a connective tissue composed of plasma and formed elements. Its main functions are transportation of oxygen, nutrients, hormones, carbon dioxide and waste; regulation of pH, temperature and water content of cells; and protection from infection and disease. The three major components of blood are plasma, red blood cells, and white blood cells. Red blood cells contain hemoglobin and transport oxygen, while white blood cells help fight infection and disease. Platelets assist in blood clotting to stop bleeding. The circulatory system efficiently carries out these vital functions through blood's composition and properties.